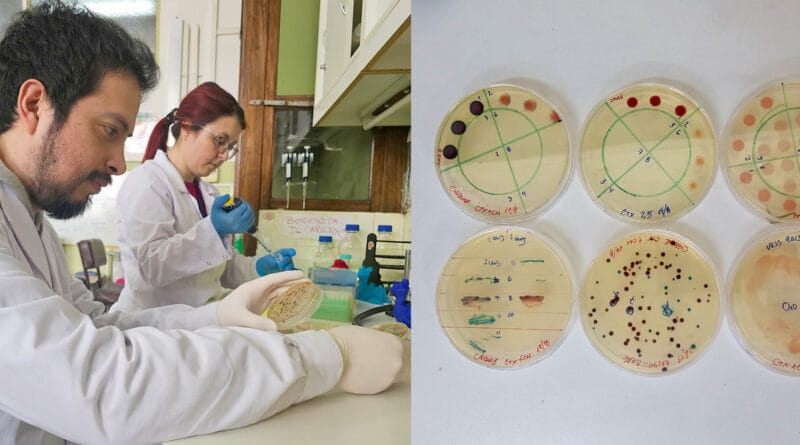

Kit de diagnóstico contra infecciones intrahospitalarias
Equipo científico de la UBA desarrolló un kit de diagnóstico rápido de resistencia a los antibióticos, lo que permitiría salvar muchas vidas. Además, están trabajando en una vacuna preventiva para evitar infecciones intrahospitalarias. Gran avance en la lucha contra las bacterias ultra resistentes.
Un equipo científico de la Universidad de Buenos Aires viene trabajando, desde hace varios años, en diferentes estrategias que permitan lidiar contra la resistencia a los antibióticos, un problema de salud pública que se lleva unas 700.000 vidas al año a nivel mundial, según la Organización Mundial de la Salud.
El mal uso de los antibióticos está llevando a que las bacterias sean cada vez más resistentes. Esto ha degenerado en el surgimiento de las llamadas superbacterias, para las cuales no hay tratamiento posible, ya que han desarrollado resistencia a múltiples antibióticos.
Los investigadores de la UBA han desarrollado un kit de diagnóstico rápido para detectar a tiempo si la infección es por una bacteria ultra resistente, y están trabajando en una vacuna para prevenir las infecciones intra hospitalarias. Contar con desarrollos nacionales como estos es clave para la salud pública del país, ya que hay linajes y genes bacterianos particulares de cada región. Así es que ambos desarrollos pueden salvar miles de vidas.
Bacterias que no aflojan
“La resistencia a los antibióticos es la capacidad que tienen las bacterias de sobrevivir frente a la presencia de un antibiótico. Esto les permite seguir produciendo infección y llegar a matar al huésped”, explicó Daniela Centrón, docente e investigadora de la Facultad de Medicina de la UBA, y directora del Instituto de Investigaciones en Microbiología y Parasitología Médica (IMPaM-UBA/CONICET).
“Esta problemática es considerada una pandemia silenciosa asociada a una altísima morbi-mortalidad, afectando la salud humana, animal, y ambiental”, agregó la investigadora. “Actualmente, la OMS la considera la mayor amenaza del siglo 21, siendo los países en vías de desarrollo los más afectados a nivel global”.
Una de las principales razones de que surja la resistencia, es que los antibióticos no siempre se usan de una forma correcta. Muchas veces se usan de forma excesiva, tanto en el ámbito de la salud humana, como en el de la veterinaria y el medio ambiente.
“Cuando se administra un antibiótico, no mata sólo a la bacteria que está causando la infección. Las mata a todas. A su vez, la presión antibiótica ejercida permite que después crezcan en el organismo las cepas que eran resistentes a esos antibióticos, al mismo tiempo que se disminuye la fortaleza de la microbiota de la persona”, explicó Centrón.
“Las bacterias adquieren resistencia a través de un mecanismo que se llama transferencia horizontal genética. Que para el universo bacteriano es algo muy frecuente. Una sola célula bacteriana puede adquirir múltiples genes de resistencia y ser resistente a muchísimos antibióticos de esa manera”, agregó.
“Hoy en día hay linajes bacterianos que tienen resistencia a todos los antibióticos disponibles en el mercado. Ahí es que se habla de bacterias con resistencia pandémica. Son las llamadas “superbacterias”, que tienen la capacidad de tener de 70 a 80 genes resistentes a antibióticos”.
“Por ello, algo muy importante de esta problemática es entender que es muy difícil de estudiar, de investigar y de combatir, porque es multifactorial y porque afecta diversos ecosistemas”, detalló la investigadora. “No está solamente a nivel clínico. Los genes de resistencia a los antibióticos también están en las aguas, en el ganado, en los alimentos. Gracias a este mecanismo de transferencia horizontal genética, las bacterias diseminan esos genes de resistencia, y lo que están compartiendo en realidad son las capacidades para sobrevivir”.

Equipo de investigación del Instituto de Investigaciones en Microbiología y Parasitología Médica de la UBA.
Detectar a tiempo
El equipo científico dirigido por Daniela Centrón, del Laboratorio de Investigaciones de Mecanismos de Resistencia a Antibióticos del IMPAM, viene investigando sobre esta problemática desde hace décadas. Actualmente, gracias a un subsidio PIDAE de la UBA, están trabajando en tres grandes objetivos. Que son el desarrollo de un Kit de detección, una vacuna para la prevención, y a la vez que buscan disminuir la resistencia a los antibióticos en el medio ambiente mediante la toma de muestras y un seguimiento.
“El kit para diagnóstico rápido de carbapenemasas ya ha sido validado en hospitales de la Ciudad Autónoma de Buenos Aires y tenemos interés por algunas empresas en comercializarlo”, contó la investigadora.
Se trata de un Kit que puede llegar a salvar muchas vidas en los hospitales, de gente que no está superando una infección. Cuando el personal de la salud se enfrenta a una situación así, por lo general saben que están frente a una bacteria multirresistente.
Es decir, que no responde a los antibióticos más comunes, entonces se debe seguir otro tratamiento. Tener este conocimiento es vital, ya que por cada hora que no se le da un tratamiento antibiótico correcto, la expectativa de vida del paciente disminuye.
En tan sólo 24 horas las posibilidades de fallecer son del 80%. Como hay tratamientos antibióticos opcionales, es importante tener una detección rápida de qué cepa resistente está causando la infección persistente.
El kit desarrollado por el equipo de la UBA funciona a partir de orina o de un hisopado rectal, entre otras muestras clínicas, y en tan sólo una hora, el personal de la salud tiene un resultado, versus los otros métodos tradicionales que pueden llevar entre 24 y 48 horas.
“Siempre lo óptimo para saber cuál es la resistencia a los antibióticos de una cepa es el antibiograma y la secuenciación genómica. Pero ahí estamos hablando como mínimo de 48 horas para lo primero, y una semana para secuenciación genómica y análisis después de tomada la muestra. Este kit permite al personal de salud una orientación rápida”, explicó Centrón. “Además, el Kit es de bajo costo, con lo cual va a poder ser usado por hospitales con pocos recursos, lo cual lleva a que no haya diferencias injustas y evitables en el acceso a la salud entre diferentes grupos de la población”.
“El inicio de la terapia antibiótica correcta en pacientes con shock séptico dentro de una hora del comienzo de la hipotensión, se relacionaba con 80% de sobrevida. Luego, por cada hora de demora, la sobrevida cae un 7,6%”, explicó Centrón. “La tecnología basada en LAMP (Loop-mediated isothermal amplification) con ciertas adaptaciones, adelanta el diagnóstico tradicional al menos 24h a partir de la muestra clínica, ya sea hisopado rectal, u orina”.
Se puede prevenir
Si bien la resistencia a los antibióticos es una problemática con la que se suele lidiar luego de detectar la infección en una persona, también se puede evitar. Gran parte de los casos más difíciles suelen ser por infecciones intrahospitalarias, así es que el equipo dirigido por Centrón está trabajando en una vacuna que pueda prevenir estos casos.
Es que, las bacterias están en todos lados, los hospitales incluidos. “Son las grandes triunfadoras de la Tierra”, comentó Centrón. Entre ellas están las multirresistentes y las “súper bacterias”, que suelen ser más comunes en hospitales de regiones con climas tropicales o subtropicales.
“Parte de nuestro proyecto de investigación, llevado adelante con el grupo del Dr. Andrés Sanchez Alberti, se centra en el desarrollo de una nueva vacuna para combatir los linajes de Klebsiella pneumoniae que se han vuelto resistentes a la mayoría de las familias de antibióticos disponibles en el mercado, lo cual dificulta su tratamiento”, contó Centrón.
«El objetivo es crear una vacuna efectiva que proteja de las infecciones en hospitales y a recién nacidos de esta peligrosa amenaza, al mismo tiempo que fortaleceremos la capacidad de nuestro país para el desarrollo de vacunas modernas”, agregó.
“Para abordar este desafío, utilizamos diversas herramientas de Inteligencia Artificial que nos permitieron identificar antígenos novedosos en esta especie, y estamos colaborando con la empresa de biotecnología Sinergium Biotech para su desarrollo. Emplearemos la tecnología de ARN mensajero (ARNm), la misma utilizada en algunas vacunas contra el COVID-19, para su producción y formulación”, explicó la investigadora.
Medio ambiente
La problemática de la resistencia de las bacterias no sólo surge por el abuso de los antibióticos entre la gente, sino también por el su uso indiscriminado en animales que luego se transforman en alimento. Esto lleva a que los antibióticos terminen contaminando los ecosistemas, las aguas, lo que se come y de esta manera tanto los antibióticos como las bacterias resistentes llegan a la gente.
Por ello, el equipo liderado por Centrón están aplicando la tecnología de los kits de detección rápida para analizar muestras ambientales, tales como aguas residuales, ríos contaminados, productos industriales, lo cual permitirá utilizarlo para establecer un programa de vigilancia de la resistencia a los antibióticos en el medioambiente.
“Estamos diseñando para el año próximo un mapa de la diseminación de la resistencia a los antibióticos . Estamos trabajando en las 15 comunas de la Ciudad de Buenos Aires, para ello”, explicó Centrón. “Se relevan desde microbiota de personas sanas, así como aguas residuales de hospitales, veredas, suelos, barandas de subte y de colectivos, y también de microbiota de perros”.
Las tres aristas en las que el equipo de la UBA trabaja, el kit para diagnóstico rápido, la vacuna para la prevención, y el monitoreo del ecosistema, son una forma de estudiar la problemática de la resistencia a los antibióticos de una forma integral.
“Uno debe estudiar el conjunto de los fenómenos involucrados. Es el marco conceptual de Una Salud, que busca analizar, planificar, implementar y evaluar acciones de salud pública estudiando todos los factores que inciden, reconociendo la interconexión entre la salud humana, animal y ambiental”, concluyó Centrón.
Y es importante que toda esta investigación se haga en y para el país. Una vacuna o un kit que sirve en Alemania, no es la misma que va a servir en Argentina. El equipo de la UBA trabajó con cepas locales, específicas de nuestra región. Estos desarrollos nacionales no se podrían realizar si no fuese porque se hacen investigaciones del y para el país.